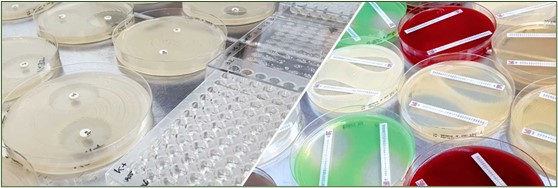

紅霉素MTS藥敏紙條助力抗擊耐藥精準(zhǔn)檢測
瀏覽次數(shù):1445 發(fā)布日期:2024-11-28
來源:本站 僅供參考,謝絕轉(zhuǎn)載,否則責(zé)任自負(fù)

紅霉素是一種廣譜抗生素,廣泛用于治療多種由細(xì)菌引起的感染,如呼吸道感染、皮膚感染、以及尿道感染等。憑借其高效的抗菌活性和相對安全的使用特點(diǎn),紅霉素在全球范圍內(nèi)被大量使用,特別是在青霉素過敏的患者中,紅霉素提供了一種有效的替代治療方案。
面臨的挑戰(zhàn):耐藥性問題日益嚴(yán)重
然而,隨著抗生素的長期使用和濫用,細(xì)菌對紅霉素的耐藥性問題變得愈發(fā)嚴(yán)重。許多傳統(tǒng)的藥敏測試方法在準(zhǔn)確評估耐藥性方面存在不足,容易導(dǎo)致治療方案的偏差,進(jìn)而影響患者的康復(fù)。因此,如何準(zhǔn)確、高效地檢測細(xì)菌對紅霉素的敏感性,成為了現(xiàn)代醫(yī)療工作中至關(guān)重要的一環(huán)。
紅霉素MTS藥敏紙條(MIC):耐藥檢測的解決方案
美德聲 紅霉素MTS藥敏紙條(MIC)獲得FDA批準(zhǔn)在美國上市。紅霉素MTS藥敏紙條在紅霉素應(yīng)用及其耐藥檢測方面展現(xiàn)了顯著的優(yōu)勢。它通過提供紅霉素的最小抑菌濃度(MIC),幫助實(shí)驗室技術(shù)人員和臨床醫(yī)生精確評估細(xì)菌對紅霉素的敏感性,確保治療的針對性和有效性。
精確測量,科學(xué)決策:MTS藥敏紙條能夠提供0.016-256 μg/mL的濃度梯度范圍,確保細(xì)菌對紅霉素的敏感性能夠被精確測量。相比傳統(tǒng)的定性測試方法,MTS藥敏紙條能夠提供更為量化的數(shù)據(jù),幫助醫(yī)生做出更科學(xué)的抗生素選擇。
提高診療效率,縮短決策時間:通過便捷的操作流程,MTS藥敏紙條大大提高了檢測效率。實(shí)驗室技術(shù)人員只需簡單地將測試條放置在接種好的瓊脂平板上,經(jīng)過適當(dāng)?shù)呐囵B(yǎng)后即可讀取結(jié)果。這種方式減少了檢測中的誤差,并顯著縮短了診療時間。
應(yīng)對復(fù)雜感染,減少抗生素濫用:紅霉素耐藥性感染通常需要更加精準(zhǔn)的抗生素選擇。MTS藥敏紙條能夠有效幫助醫(yī)療團(tuán)隊在復(fù)雜感染中選擇合適的抗生素,避免由于抗生素濫用而導(dǎo)致的進(jìn)一步耐藥性問題,促進(jìn)合理用藥。
結(jié)果讀取與解讀
在使用紅霉素MTS藥敏紙條時,需根據(jù)抑菌橢圓與試紙的相交位置讀取MIC值。如果抑菌橢圓在梯度的下限或上限之外,則分別讀取為低于或高于該范圍的值。對于如金黃色葡萄球菌等耐藥菌的檢測,結(jié)果需要根據(jù)FDA的標(biāo)準(zhǔn)進(jìn)行分類和解讀,以確保治療方案的有效性。
精準(zhǔn)醫(yī)療的助推器
在對抗耐藥性細(xì)菌的戰(zhàn)斗中,美德聲紅霉素MTS藥敏紙條(MIC)是精準(zhǔn)醫(yī)療的重要工具。它不僅為實(shí)驗室技術(shù)人員提供了可靠的數(shù)據(jù)支持,更為患者帶來了更高的康復(fù)可能性。通過精準(zhǔn)檢測、科學(xué)選擇抗生素,我們有望減少耐藥性問題的擴(kuò)散,助力未來的抗菌治療更加有效。
應(yīng)用方向
美德聲紅霉素MTS藥敏紙條(MIC)適用于以下應(yīng)用方向:
- 臨床微生物實(shí)驗室:在醫(yī)院及診所的臨床實(shí)驗室中,用于檢測細(xì)菌對紅霉素的敏感性,幫助醫(yī)生選擇最合適的抗生素治療方案。
- 公共衛(wèi)生監(jiān)測:用于公共衛(wèi)生系統(tǒng)中的細(xì)菌耐藥性監(jiān)測,幫助及時發(fā)現(xiàn)耐藥菌株的出現(xiàn)并采取相應(yīng)的防控措施。
- 科研機(jī)構(gòu):適用于研究機(jī)構(gòu)對紅霉素及其耐藥機(jī)制的深入研究,提供精確的MIC數(shù)據(jù)以支持科學(xué)研究。
- 制藥企業(yè)的研發(fā)部門:在抗生素研發(fā)過程中,測試新抗菌藥物與紅霉素聯(lián)合使用的效果,確保藥物的開發(fā)符合臨床需求。
產(chǎn)品清單
| 產(chǎn)品編號 |
產(chǎn)品名稱 |
| 920511 |
紅霉素MTS藥敏紙條(MIC) (0.016-256 μg/mL, 10條/盒) |
結(jié)語
紅霉素作為抗感染的“老兵”,在醫(yī)療領(lǐng)域依然扮演著重要的角色。而通過像美德聲紅霉素MTS藥敏紙條(MIC)這樣的現(xiàn)代工具,我們能夠更好地掌控其應(yīng)用效果,應(yīng)對耐藥性挑戰(zhàn)。精準(zhǔn)檢測、合理用藥,是我們共同追求的目標(biāo),也是保障每一位患者健康的關(guān)鍵所在。
訂購請聯(lián)系美德聲400 806 6607;專業(yè)服務(wù)專業(yè)!